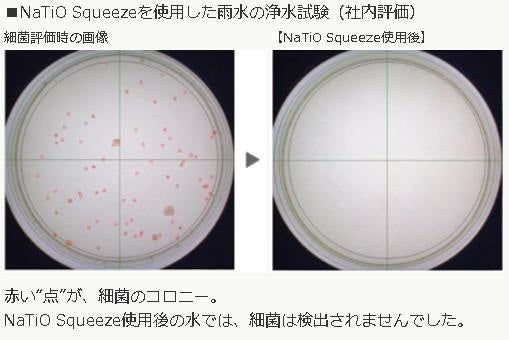

防災用携帯型浄水ボトル NaTiO Squeeze(ナティオ スクイーズ)発売
トクラス株式会社(静岡県浜松市、代表取締役社長:小泉 和弘)は、災害時等に最大10日間貯留した水道水や雨水を、飲用可能な浄水にすることができる、防災用携帯型浄水ボトル「NaTiO Squeeze(ナティオ スクイーズ)」を、3月11日より発売いたします。トクラスと信州大学が共同開発した高性能の浄水材料を使用しています。コンパクトで携帯性がよく耐衝撃性も高いので、防災用だけではなくアウトドア等様々なシーンで活用いただけます。
※JWPAS S(2014)「災害用浄水機器に関する性能試験方法の規格」(一般社団法人 浄水器協会)に示された、JWPAS S.120「災害用浄水機器Ⅱ類性能試験方法」により、細菌除去性能を試験。生菌数は測定されませんでした。[分析試験:(一財)日本食品分析センター(第21092735001-0101号)]
② 使用期限5年、コンパクトに折りたためて保管しやすい
③ 耐衝撃性が高く、人体にも優しい素材
シリコンゴムとポリカーボネートを使用しているので、高い耐衝撃性能を備えます。また、BPAフリーなので人体にも優しい製品です。
本体セットで1週間分(1人分、1日あたり3リットルの使用を想定)の飲用水をつくることができます。中空糸膜と浄水パック(別売)を交換することで、繰り返しご使用いただけます。
●販売価格:7,480円(税込)
●セット内容:本体、中空糸膜2個、浄水パック14個
●本体容量︓1リットル
●販売:
トクラス公式オンラインショップ
https://shop.toclas.co.jp/
トクラス楽天市場店
https://www.rakuten.ne.jp/gold/toclas-water/
●除去できる物質
0.2μmより大きな粒子、遊離残留塩素、溶解性鉛、陰イオン界面活性剤、一般細菌、大腸菌
防災用携帯型浄水ボトル「NaTiO Squeeze(ナティオ スクイーズ)」
- NaTiO Squeeze(ナティオ スクイーズ)の特長
信州大学とトクラスが共同開発した重金属を吸着できる「三チタン酸ナトリウム」と活性炭を配合した浄水パックと、細菌や濁り等を除去できる中空糸膜の二段階のろ過構造。コンパクトでありながら高性能で、最大10日間貯留した水道水や雨水等を、飲用可能な美味しい浄水にすることができます。
※JWPAS S(2014)「災害用浄水機器に関する性能試験方法の規格」(一般社団法人 浄水器協会)に示された、JWPAS S.120「災害用浄水機器Ⅱ類性能試験方法」により、細菌除去性能を試験。生菌数は測定されませんでした。[分析試験:(一財)日本食品分析センター(第21092735001-0101号)]
② 使用期限5年、コンパクトに折りたためて保管しやすい
コンパクトに折りたためて保管しやすい
③ 耐衝撃性が高く、人体にも優しい素材
シリコンゴムとポリカーボネートを使用しているので、高い耐衝撃性能を備えます。また、BPAフリーなので人体にも優しい製品です。
- 使用方法

本体セットで1週間分(1人分、1日あたり3リットルの使用を想定)の飲用水をつくることができます。中空糸膜と浄水パック(別売)を交換することで、繰り返しご使用いただけます。

- 商品詳細

●販売価格:7,480円(税込)
●セット内容:本体、中空糸膜2個、浄水パック14個
●本体容量︓1リットル
●販売:
トクラス公式オンラインショップ
https://shop.toclas.co.jp/
トクラス楽天市場店
https://www.rakuten.ne.jp/gold/toclas-water/
●除去できる物質
0.2μmより大きな粒子、遊離残留塩素、溶解性鉛、陰イオン界面活性剤、一般細菌、大腸菌
このプレスリリースには、メディア関係者向けの情報があります
メディアユーザーログイン既に登録済みの方はこちら
メディアユーザー登録を行うと、企業担当者の連絡先や、イベント・記者会見の情報など様々な特記情報を閲覧できます。※内容はプレスリリースにより異なります。
すべての画像
- 種類
- 商品サービス
- ビジネスカテゴリ
- 環境・エコ・リサイクルアウトドア・登山
- ダウンロード
